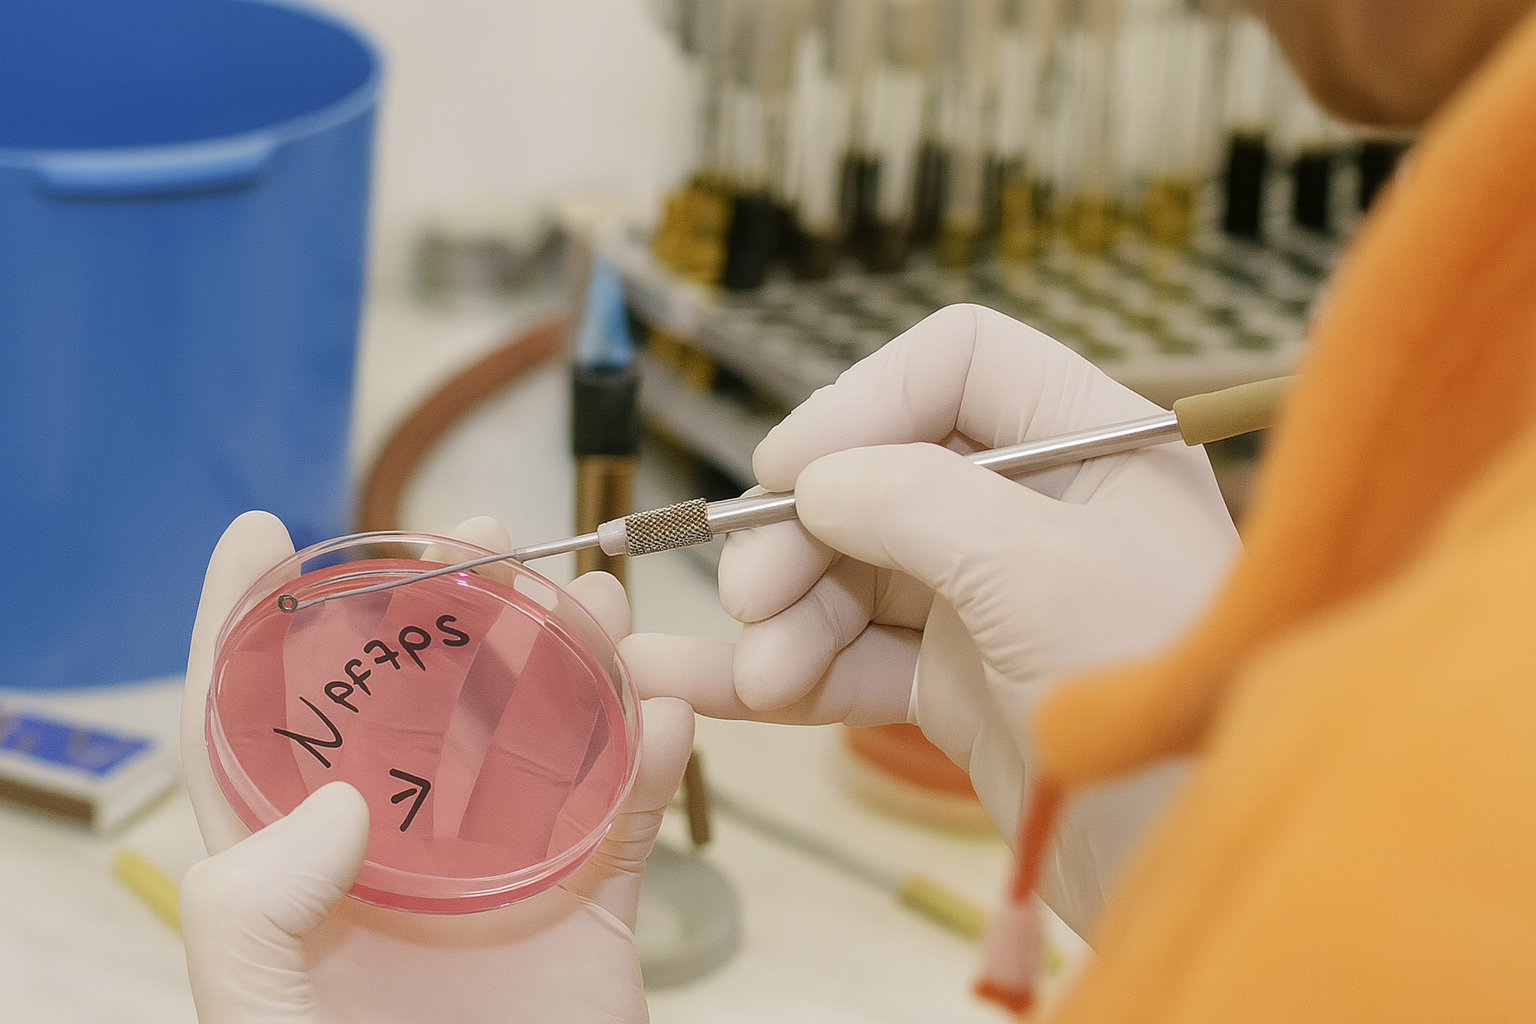
Očkovanie vzorky

- Detaily
- Analýza akrylamidu v potravinách
- Analýzy v čokoláde
- Analýza GMO
- Analýza krmív
- Analýzy medu a medoviny
- Analýzy mliečnych výrobkov
- Analýza mykotoxínov
- Analýzy pitnej vody
- Analýzy prídavných látok
- Analýzy procesných kontaminantov v potravinách
- Analýza reziduí antibakteriálnych látok v surovinách živočísneho pôvodu - tkanivá, mlieko, vajcia, med
- Analýza vína
- Detekcia pohlavia vtákov
- Laboratórna diagnostika krvných parazitóz
- Laboratórna diagnostika v chovoch hovädzieho dobytka
- Ponuka analýz v skúšobnom laboratóriu Prešov
- Ponuka analýz povrchových vôd a vyšetrenia rýb
- Ponuka bakteriologických vyšetrení
- Ponuka parazitologických vyšetrení
- Ponuka vyšetrení pre domácich miláčikov
- Včely
- Veterinárna toxikológia
- Detaily
Činnosť oddelenia serológie a virológie:
- komplement - fixačný test
- rýchla sklíčková aglutinácia
- pomalá aglutinácia
- imunodifúzny test
- ELISA testy
- vírusneutralizačný test
- vyšetrenie krvného obrazu
- izolácia vírusu
- identifikácia vírusu
- infekčné ochorenia domácich zvierat:
- u psov: toxoplazmóza, leptospiróza, parvoviróza, lymská borelióza, adenovírus, koronavírus, psinka, brucelóza, ehrlichia canis, babesia canis, neospora canis, herpersvírus, rotavírus, chlamydióza
- u mačiek: leukémia mačiek (FeLV), vírusová imunodeficiencia mačiek (FIV), infekčná peritonitída a pleuritída mačiek (FIP), herpesvírus, chlamydióza
- hematologické vyšetrenia: hemoglobín, hematokrit, počty krviniek a trombocytov, leukogram, krvné parazity
- biochemické vyšetrenia z krvi: močovina, kreatinín, kys. močová, celkové bielkoviny, albumín, bilirubín, AST, ALT, GMT, cholesterol, P, Na, K, Ca, Mg, chloridy, T3, T4
- progesterónový test - nastavenie optimálnej doby pripúšťania u fien
NRL pre choroby rýb:
- parazitologické vyšetrenia
- bakteriologické vyšetrenia
- virologické vyšetrenia
- chemické vyšetrenia
- toxikologické vyšetrenia
Kontakt
Oddelenie serológie a virológie - vedúci oddelenia
MVDr. Miriam Maceková, telefón: 043/5837 165, 130- Detaily
Činnosť oddelenie patologickej anatómie
- pitva uhynutých zvierat a patologicko anatomické vyšetrenie doručeného sekčného materiálu (orgány a orgánové sústavy)
- histopatologické vyšetrenia tkanív, vrátane nádorových ochorení
- imunofluorescenčné vyšetrenie na dôkaz antigénu vírusu besnoty, vrátane v prípade expozície vykonáva biologický pokus v zmysle nariadenia OIE
- komplexná diagnostika príčin ochorenia a úhynov v spolupráci s ostatnými oddeleniami ústavu (bakteriológia, parazitológia, mykológia, virológia, serológie, chémia, biochémia, toxikológia)
- vyšetruje hospodárske, domáce a voľne žijúce zvieratá s následnou konzultačnou a poradenskou činnosťou. V prípade požiadavky zabezpečuje osobnú návštevu v predmetnom chove so zabezpečením odberu vzorky na ďalšie laboratórne šetrenie
- vypracuváva na základe požiadavky: odborné posudky, stanoviská a zabezpečuje vyhotovenie fotodokumentácie
- zabezpečuje v prípade voľných pracovných dní a sviatkov nepretržitú pohotovostnú službu
- koprologické vyšetrenie trusov všetkých zvierat (hospodárske, voľne žijúce)
- vyšetrenia kožných zoškrabov
- vyšetrenia na prítomnosť tkanivových parazitov
- taxonomické určenie parazita
- vyšetrenia parazitov včiel - nosematóza, varroáza, akarapidózu, malý úľový chrobák
- vyšetrenia na leptospirózu - MAL reakciou
- vyšetrenia na toxoplazmózu (koprologické, sérologické)
- parazitologická pitva
- vyšetrenia na svalovca tráviacou a kompresorickou metódou (podľa Nariadenia EK)
- vyšetrenia trichomonádovej nákazy hovädzieho dobytka a holubov
- vyšetrenie na kryptosporídie
- vyšetrenie močového sedimentu



Kontakt
Oddelenie patologickej anatómie - vedúci oddelenia
MVDr. Michaela Brincko-Červenská, telefón: 043/5837125- Detaily
Činnosť oddelenia skríningových metód
- screeningové vyšetrenie rezíduí veterinárnych liekov metódou CHARM II
- sulfonamidy (med, živočíšne tkanivá, mlieko, vajcia)
- streptomycín a dihydrostreptomycín (med, živočíšne tkanivo - králik, vajcia)
- tetracyklíny (med, živočíšne tkanivá, mlieko, vajcia)
- betalaktámy (živočíšne tkanivá, mlieko, vajcia)
- screeningové vyšetrenie rezíduí veterinárnych liekov metódou ELISA
- streptomycín a dihydrostreptomycín (med, živočíšne tkanivá, mlieko)
- chloramfenikol (med, živočíšne tkanivá, mlieko, vajcia)
- stanovenie mykotoxínov v potravinách a krmivách
- aflatoxíny
- ochratoxín A
- fusáriové mykotoxíny (deoxynivalenol, T-2 toxín, zearalenon)
- T-2 toxín
- stanovenie alergénov v potravinách
- celkové mliečne proteíny
- srvátkový proteín (β-lactoglobulin)
- mliečny kazeín
- sójový proteín
- peanut (arašidový) proteín
- hazelnut (lieskovoorieškový) proteín
- vaječný proteín
- glutén (lepok)
- dôkaz druhu mäsa v mäse a mäsových výrobkoch
- dôkaz hovädzích proteínov
- dôkaz hydinových proteínov
- dôkaz bravčových proteínov
- dôkaz prítomnosti špecifického rizikového materiálu v mäse a mäsových výrobkoch
- dôkaz efektívnosti zahriatia mäsokostných múčok
- dôkaz enterotoxínu Staphylococcus aureus a jeho typizácia
- dôkaz prítomnosti kravského mlieka v ovčom a kozom mlieku a v ovčom a kozom syre
Kontakt
Oddelenie screeningových metód
MVDr. Miriam Maceková, telefón: 043/5837130, 043/5837165- Detaily
Činnost oddelenia hygieny potravín
Oddelenie hygieny potravín najmodernejšími postupmi zabezpečuje v oblastiach hygieny potravín (senzorika, mikrobiológia, potravinárska chémia) a v ďalších súvisiacich disciplínach, s využitím moderného prístrojového vybavenia vyšetrovanie potravinárskych komodít so zreteľom na ich zdravotnú nezávadnosť a na dodržanie správnych resp. deklarovaných technologických postupov pri ich výrobe, ďalej sa overuje dodržiavanie výrobných a pracovných postupov ovplyvňujúcich vlastnosti produktov ako je trvanlivosť a pod., kontroluje sa dodržiavanie hygieny a asanácie v prevádzkach a pomáhajú sa objasniť príčiny zistených závad z hľadiska hygienickej akosti živočíšnych produktov.
a potravinový ústav Bratislava
Oddelenie vykonáva:
- komplexné senzorické analýzy
- komplexné mikrobiologické a mykologické skúšky a analýzy potravín živočíšneho a rastlinného pôvodu a surovín určených na výrobu potravín v zmysle požiadaviek potravinového kódexu a platnej legislatívy
- skúšky a analýzy na zdravotnú nezávadnosť surovín a hotových výrobkov v rámci systému HACCP
- mikrobiologické analýzy pre pravidelné kontroly procesu hygieny výroby prevádzkovateľov potravinárskych podnikov a kontrolu hygieny na bitúnkoch v súlade s požiadavkami stanovenými Nariadením komisie (ES) č.1441/2007
- mikrobiologické analýzy pre pravidelné kontroly procesu hygieny výroby v súlade s požiadavkami stanovenými Nariadením komisie (ES) č.2076/2005 pre podniky vyrábajúcich mleté mäso,mäsové polotovary,mechanicky separované mäso a Nariadením komisie (ES) č.1441/2007
- vyšetrenia spojené s uvádzaním potravín do obchodného reťazca, overovanie trvanlivosti, predĺženia doby spotreby
- vyšetrenie sterov z potravinárskych prevádzok na kontrolu účinnosti dezinfekcie, príp. overenie účinnosti používaných dezinfekčných prostriedkov
- vyšetrovanie pôvodcov zoonóz na úrovni Národných referenčných laboratórií (Listeria monocytogenes, Campylobacter jejuni, Yersinia enterotolitica, Staphylococcus aureus a stafylokokový enterotoxín)
- analýzy potrebné pre export a import potravín a surovín
- analýzy podľa požiadaviek zákazníka
- poradenskú a konzultačnú činnosť v oblasti vyvíjania nových potravinárskych výrobkov vrátane označenia potravín podľa platnej legislatívy
Činnosť oddelenia zabezpečuje:
- laboratórium hygieny mäsa a mäsových výrobkov
- senzorické hodnotenie a posúdenie označenia výrobku
- mikrobiologické vyšetrovanie podľa požiadaviek potravinového kódexu a platnej legislatívy
- overenie zhody medzi skutočným a deklarovaným zložením (dôkaz druhových špecifických bielkovín využitím PCR metód a ELISA metód,stanovenie obsahu sóje,falšovanie a autentifikácia mäsových výrobkov,kontrola použitia GMO)
- posudzovanie nových technologií výroby mäsových polotovarov a mäsových výrobkov
- stanovenie rezíduí inhibičných látok
- laboratórium hygieny mlieka a mliečnych výrobkov
- senzorické hodnotenie a posúdenie označenia výrobku
- mikrobiologické vyšetrovanie podľa požiadaviek potravinového kódexu a platnej legislatívy
- overenie zhody medzi skutočným a deklarovaným zložením (dôkaz druhových špecifických bielkovín využitím PCR metód a ELISA metód,falšovanie a autentifikácia mlieka a mliečnych výrobkov)
- posudzovanie nových technologií výroby mliečnych výrobkov
- stanovenie rezíduí inhibičných látok
- laboratórium ostatných potravinárskych produktov (vrátane výrobkov rastlinného pôvodu)
- senzorické hodnotenie a posúdenie označenia výrobku
- mikrobiologické vyšetrovanie podľa požiadaviek potravinového kódexu a platnej legislatívy
- overenie zhody medzi skutočným a deklarovaným zložením (dôkaz druhových špecifických bielkovín využitím PCR metód a ELISA metód,falšovanie a autentifikácia výrobkov, kontrola použitia GMO)
- posudzovanie nových technologií výroby ostatných potravinárskych produktov
- stanovenie rezíduí inhibičných látok (vajcia,med)
Zoznam mikrobiologických skúšok vykonávaných v laboratóriu mikrobiológie:
- stanovenie celkového počtu mikroorganizmov
- stanovenie počtu koliformných baktérií
- stanovenie počtu kvasiniek a plesní
- dôkaz prítomnosti Salmonella spp
- stanovenie počtu koagulázopozitívnych Staphylococcus aureus
- stanovenie počtu Clostrídium perfringenes
- stanovenie počtu mezofilných anaeróbnych spórotvorných mikroorganizmov
- stanovenie počtu Clostrídium perfringens
- stanovenie počtu Bacillus cereus
- stanovenie počtu β-d-glukuronidázopozitívnych Escherichia coli
- dôkaz prítomnosti Escherichia coli O 157(VTEC,verotoxín produkujúce E.coli)
- stanovenie počtu Enterobacteriaceae
- dôkaz prítomnosti Enterobacteriaceae
- dôkaz pritomnosti Enterobacter sakazakii(dojčenská výživa)
- stanovenie počtu Enterokokov
- stanovenie počtu Lactobacillus sp.
- stanovenie počtu Leuconostoc sp.
- stanovenie počtu osmofilných kvasiniek
- stanovenie počtu psychrofilných mikroorganizmov
- stanovenie počtu Pseudomonas aeruginosa
- stanovenie počtu Listeria monocytogenes
- dôkaz prítomnosti Listeria monocytogenes
- dôkaz prítomnosti Vibrio parahaemolyticus
- dôkaz prítomnosti Campylobacter sp.
- dôkaz prítomnosti Yersinia enterolitica
- dôkaz prítomnosti Proteus sp.
- stanovenie počtu proteolytických mikróbov
- stanovenie počtu lipolytických mikróbov
- sulfitredukujúce klostrídie
- rýchle metódy na stanovenie patogénov Salmonella sp.,Listeria monocytogenes,Campylobacter sp.,E.coli O157 imunofluorescenčnou metódou VIDAS
- termostatová skúška
- jatočné zvieratá podľa požiadaviek Nariadenia Komisie(ES) č.1441/2007:deštruktívna metóda,Salmonella sp.-abrazívna metóda
- stanovenie mikrobiálnej kontaminácie plôch,prevádzkových zariadení a obalov sterovou technikou
Kontakty
Oddelenie hygieny potravín - vedúca oddelenia
MVDr. Lenka Cabanová PhD., telefón: 043/5837164 e-mail,